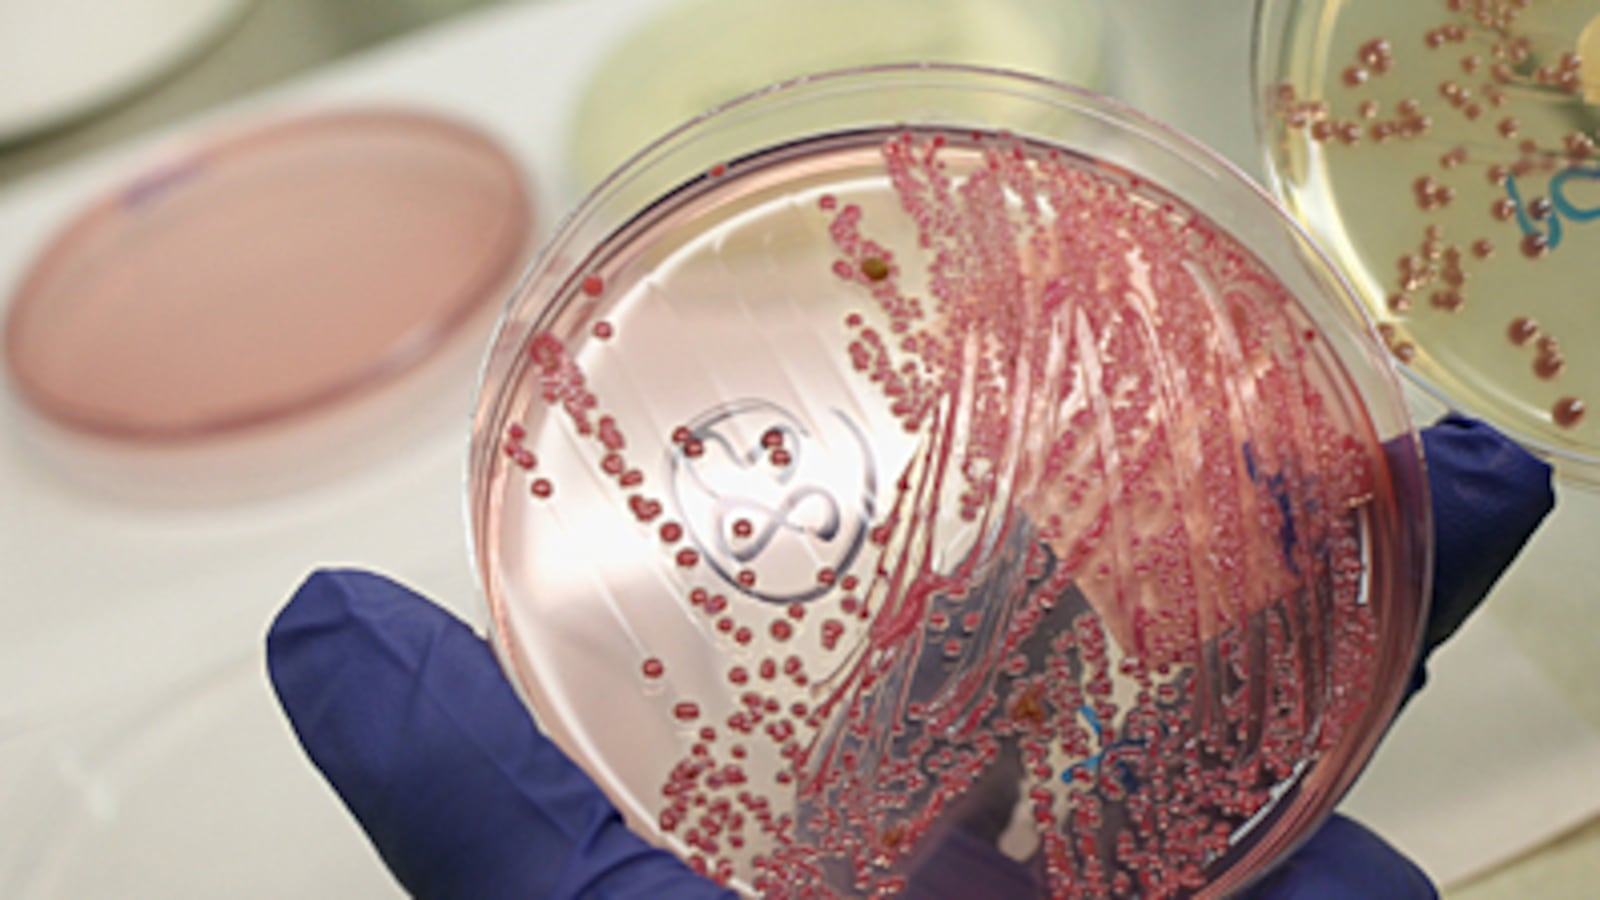
articles/2010/08/12/superbug-facts-to-know-as-ndm-1-emerges/superbug_185151_qsoidl

Scientists say the deadly E. Coli strain that has struck Europe contains a rare “glue” that helps it bind to people’s intestines—and may be the most toxic variety to ever hit humans. The Daily Beast breaks down 10 surprising facts about superbugs.
Scientists studying the deadly E. coli strain that has struck Europe say it contains a rare “glue” that helps it bind to people’s intestines. That, combined with especially poisonous bacteria, may make it the most deadly strain to ever hit humans. So far 17 people have been killed in Europe, and 1,500 more have been sickened. After it sticks to the intestinal walls, the E. coli pumps out toxins, and can attack the kidneys and cause coma, seizure, and stroke.
We’ve broken down 10 surprising facts about “superbugs.”

1. Superbugs Spread the Most in Hospitals.
It’s true: The hospital is one of the easiest places to get a superbug, as it presents so many potential breeding grounds. Scientific American estimates that nearly 100,000 people die each year from bugs they pick up in health-care facilities, and almost 1.7 million patients contract hospital infections annually, according to the CDC. How does this relate to superbugs? Well, they evolve by becoming resistant to antibiotics, and heavy antibiotic use in hospitals is one of the major factors in their growth. Also, think about how frequently there are open wounds in hospitals, or tubes carrying blood: All are breeding grounds for superbugs. The latest superbug, NDM-1, has a shadowy past with hospitals. British doctors said 14 of the patients found to have the virus had been hospitalized in India or Pakistan recently, mostly for cosmetic surgery. NDM-1 is also resistant to most antibiotics and can easily travel from one bacteria to another—meaning it can travel easily via other bacterial infections.
2. Superbugs Love College Campuses.
Ah, college. So many of those first “shared experiences” that are considered the cornerstone of American college life—communal showers, waiting to wash the sheets until returning to mom and dad’s, the cafeteria’s frequently-used trays, beer pong—are breeding grounds for superbugs. In 2007, nine athletes from Iona College in New York contracted methicillin-resistant Staphylococcus aureus or MRSA, a staph infection commonly associated with hospitals.
3. Superbugs Can Travel in Food.
Since superbugs thrive in any living organism, it’s only natural to assume they can be carried in food. It’s just not something you really want to think about. The same things that have caused superbugs in humans—overuse of antibiotics, unclean instruments, close quarters—are key in their growth in animals. But one of the biggest problems with superbugs in animals is a lack of testing in processed food plants. Recent studies have found the superbug MRSA in retail cuts of pork, chicken, beef and other meats not only in the U.S., but in Europe and Asia as well. And earlier this year, researchers said China’s excessive use of antibiotics in its farm production stood to be a major cause of superbug growth in the food chain.
4. Cell Phones Cause Superbug Outbreaks in Hospitals.
In 2009, researchers in Turkey found that 95 percent of doctors’ and nurses’ cell phones had at least one strain of bacteria, and 35 percent had two. So, OK, not all bacteria is not a superbug, right? No, but nearly one in eight of these cell phones were found to harbor MRSA, the rampant superbug found in hospitals. And cell phones can be particularly deadly; not only are they infrequently cleaned, but they are touched by hands, ears, and mouths. Science Daily recommends that everyone undergo strict infection control methods to prevent the spread of superbugs via cell phones, and remember to regularly clean your phone or think about the phone you are borrowing.
5. Gonorrhea Could Be the Next Superbug.
When exactly gonorrhea burst onto the scene is not known, and although it’s existed for centuries, scientists say it has a fair chance of being the next superbug. The World Health Organization estimates there are 340 million new cases worldwide of all sexually transmitted diseases, including gonorrhea, every year in people among the ages of 15 to 49. What makes gonorrhea dangerous is that it has very few symptoms until the disastrous ones, such as ectopic pregnancy and pelvic inflammatory disease. But this is not the only factor in pushing gonorrhea toward a superbug—also there are very few new drugs available because it is not as deadly an STD as HIV/AIDS or even syphilis. As a result, doctors normally treat gonorrhea that is drug resistant by piling on more antibiotics, causing the bacteria to grow stronger and stronger.
6. Fecal Transplant May Be a Cure for Some Superbugs.
Clostridium difficile, or C. diff or C. difficile for short, is a superbug that arises when patients are taking antibiotics that kill the good bacteria in the intestines that would normally fight it off. In healthy people, the good bacteria is in their fecal matter, so if a patient can get stool samples—usually from a close relative—a doctor will test them for other diseases and administer them through an enema. The procedure is not only controversial, it’s extremely unpopular because it sounds so disgusting. But doctors say the process only takes an hour to cure the disease. “It cured me. This procedure cured me, and one of the reasons I agreed to do this story—because it’s difficult to talk about—is I know many people die from C. difficile and I want people to know there is hope when you have this illness,” said Toronto resident Marcia Munro.
7. Marijuana May Help Treat Superbugs.
Should we all just chillax about superbugs? Perhaps. New research shows that marijuana may help to treat various antibiotic-resistant infections. Indeed, five cannabinoids “showed potent antibacterial activity” in fighting two widespread strains of MRSA found in British hospitals, researchers at Italy’s Universita del Piemonte Orientale and Britain’s University of London School of Pharmacy reported in the Journal of Natural Products. The practical solution may lie, at least in part, in a “topical, whole-cannabis treatment,” said Robert Melamede, Ph.D., head of the American-based Cannabis Science Inc.
8. GlaxoSmithKline Has Made Progress Toward a Cure.
With scientific organizations like the American Academy of Microbiology dubbing antibiotic resistance “an international pandemic,” you might think that drug companies would be springing into action to find a cure, yet Big Pharma has been slow to respond. Earlier this month, however, GlaxoSmithKline announced progress in outsmarting superbugs in the journal Nature, generating headlines and hope. The pharma giant reports that it’s creating an experimental compound that attaches to an enzyme in bacteria—and prevents the bacteria from reproducing. While superbug-resistant antibiotics like Cipro work in the same way, the new compound attaches to the enzyme in a different spot than existing drugs, working around the tolerance. Researchers still have to transform the compound into a medicine, though, and then begin testing it on humans.
9. Paint Can Kill Some Superbugs.
Superbugs may still be resistant to antibiotics, but researchers at the University of South Dakota have invented a paint (yes, paint) that brings the nasty buggers to their knees, so to speak; a coating strong enough to kill MRSA and other lethal bacteria. The substance serves the dual purpose of decorating the walls of homes, businesses, and hospitals—and disinfecting those same structures with “potent antimicrobial activities,” according to a 2009 study in the American Chemical Society’s journal, Applied Materials & Interfaces. While the paint’s powers are limited—it won’t completely prevent the transmission of superbugs, just reduce it, and it only protects against a limited range of microorganisms—its creators claim that it provides a promising new tool against the germs.
10. One of the Most Powerful Superbugs Is Being Contained.
Yes, a new superbug is descending on hospitals across the globe, but the good news is that one of the most worrisome strains—MRSA, which has become resistant to antibiotics including methicillin, penicillin, and amoxicillin—may now be dimming. According to a new report from the Centers for Disease Control and Prevention, from 2005 to 2008, cases of MRSA fell significantly. Instances of hospital-related infections saw a 28 percent decrease, and health care-related infections saw a 17 percent decrease. While the reasons for the drop are still unclear, the report credits better measures for containing the spread of disease, among other factors.